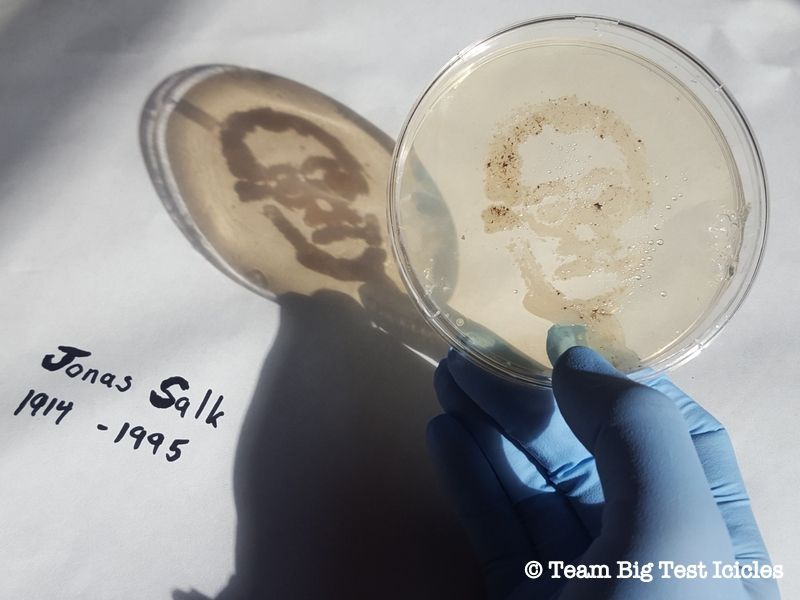

Topple a Statue of King George at MCNY's New Revolutionary Exhibit
Explore the seven years of NYC history when the city was occupied, brutalized, and eventually, liberated.

The demise of GISHWHES was greatly exaggerated by Misha Collins himself when he announced the end of his charity scavenger hunt in 2017. Collins, who plays Castiel on Supernatural and known internet troll, murdered the old iteration of the scavenger hunt by changing the name to GISH. Basically, he chopped off half of the name and created an app. Super dramatic, right?
What was formerly known as The Greatest International Scavenger Hunt the World Has Ever Seen has since been adapted to the less obnoxiously long title of Greatest International Scavenger Hunt. To be fair, Collins did seem to have a stronger revamp in mind, as he teased a partnership with a major tech company following the cancellation announcements in 2017, but it never came to fruition. Instead, GISH just had a breakup with WHES.
The annual scavenger hunt began in 2011 when Collins enlisted his followers to partake in a bizarre scavenger hunt with the weirdest tasks you could possibly think of. There are two things people need to know about Misha Collins: He’s the weirdest dude on the internet and he has a huge passion for charity. Add the two together and you get GISH.
Inspired by a scavenger hunt played at his college, The University of Chicago, Collins was determined to create a scavenger hunt that brought the internet together. He designed GISH(WHES) to prompt participants to bring forth as much good in the world as they possibly could—all while wearing dresses made of cheese or popcorn.
Every year, GISH sets its sights on several main charitable endeavors. A portion of the registration fee to join the hunt goes toward that charitable goal. This year, both tasks were especially personal to the GISH family. Giles Duley, photojournalist and IED survivor, has been working with Misha Collins and GISH(WHES) for years. Even after losing both legs and an arm, Duley continues to share photos of the devastation war brings to the world and its inhabitants. He uses his experience war experience to bring awareness to the issue through GISH and beyond.
The United States dropped over 2 million bombs on Laos, a small country in Asia, between 1964 and 1973. Most of the bombs are still littered across the country, waiting to be detonated. The bombs are spherical and to children, they look like toys. Over 8,000 children have been injured or killed from the undetonated bombs—almost half of the 20,000 victims in total.
GISH registration costs managed to raise enough money to clear bombs in 25 family farms. Given the high number of children who lose their lives to these bombs that were dropped before they were even born, GISH aimed to raise money for prosthetic limbs. On top of that, a portion of registration costs also go toward Misha Collins’ charity, Random Acts—an organization focused on spreading kindness through hunger campaigns, building schools, helping teachers, and any other act of kindness you could possibly think of.
The fundraiser within the scavenger hunt set a $200,000 goal to clear even more farms and fund prosthetics for affected kids. GISH raised a total of $241,861 in less than a week. This is what GISH is all about. Sure, teams strive to spread some weird during the duration of the hunt, which usually takes place in the first week of August. Everyone competes with tasks like making ugly Christmas sweaters into bathing suits or partaking in Stormtrooper acrobats, but at its core, GISH is about changing the world for the better.
Be it visiting someone in a nursing home, donating to an important cause, becoming an activist, getting involved in politics, or brightening the day of someone in the hospital, those are the items that GISHers, and the people whose lives they touched, remember the most.
Untapped Cities is not affiliated with official GISH judging, which will likely be posted around November. This year, the winning team will head to Laos with Misha Collins. Usually, the trip is purely about having fun, but this year, the lucky winners will get a chance to see their fundraising efforts in action—and maybe spread a little kindness while they’re there.
Here are 28 of the best, most inspiring items of GISH 2019. Whether these teams submitted a stunning photo, have a great story to tell, or worked hard to change someone’s life for the better, these GISHers did a remarkable job during the 2019 Hunt.

“Item 34: The Federation of Stormtroopers has been officially sponsored by the X Games this year. Let’s see a highlight from one of their competitions with the stormtrooper participating in an extreme sport.”
Shell and Jon of the Illusive Yetis enlisted Jon’s friend Rob to partake in an epic feat of Stormtrooper skateboarding. Shell and Jon claim that Rob had a difficult time pulling off the tricks in the mask, but that’s obviously just a cover story. Rob is definitely Force-sensitive.
The daring display of Republic athleticism was photographed by Rob’s girlfriend Bailey at Shaw Millennium Skatepark in Calgary, Alberta Canada. Is it a coincidence that Millennium is in the title of the park? The conspiracies are strong with this one.

“Item 114: The best part about being in the hospital is the couture. Hold a hospital gown fashion show in your local hospital to show off red-carpet-worthy hospital gowns of your creation. Glam it up and walk (or roll) the runway with any patients that might be able and willing to participate… and don’t forget the slip-proof socks!”
Every year, GISH includes a hospital item meant to put smiles on the faces of hospital patients and their visitors all around the world. This year was no exception.
Tree, from the team MischiefManaged, said: “Mom’s been in the hospital all of GISH this year, so number 114 was my favorite item, as we were able to get her unhooked from all her lines and out for a short Johnny Fashion Runway Show. She’s 87, and as sick as she is, she rocked it. As I write this, Mom hasn’t eaten solid food in 14 days and is receiving nutrition through a pic line—but she’s still the Gishiest seasoned citizen I know!”

Michaela of team Mishap said: “I was fortunate enough to claim an item that gave me another excuse to help break the monotony of a hospital stay for my grandmother.”
She continued with, “She’s currently going through her first round of chemo and while she doesn’t like wearing hospital gowns herself, she was more than happy to do her very best ‘model pose’ for my picture! The look on her face when I walked in the room wearing this was priceless.”
While GISH is often about spreading random acts of kindness, it is often incredibly healing for families. Items like this give GISHers the opportunity to make incredible and heartwarming memories that last a lifetime. When your family is going through a rough time, smiling together is a welcome escape.

“Item 31: In the past, stained glass windows usually depicted flowers or devotional symbols like angels and saints. But modern culture venerates a different group. Create a stained glass window of a Kardashian, famous Instagram Influencer, or similar personality with more than 4 million followers.
It must be someone who is worshipped simply for being worshipped for being famous. You may not use anyone from the cast of Supernatural. Bonus points if it’s installed in an actual cathedral.”
Megan of the Illusive Yetis said: “The Holy Tears of St. James (Charles) was my favorite item to make in 2019. When I’m not doing GISH, I work with teen volunteers on community projects. My students keep me up on youth trends such as the rise of the 20-year-old beauty influencer, James Charles, who has over 15 million followers on YouTube.
She went on to say, “Charles has made a career out of looking fabulous in makeup, inciting drama, and weeping on camera. The stained glass work, made with artist tape and alcohol-based ink on framed glass, envisions Charles as a modern gay Byzantine icon.”
Pastor Layne Beamer, at First Christian Church of Whittier, helped Megan light the sanctuary shot. “Holy Tears” now hangs in an upstairs classroom of the church and will make an appearance at Queer Prom in the Fellowship Hall in September.
Even when GISH items don’t require teammates to make a difference, they usually find a way. What could have been a frivolous portrait of a Kardashian turned into a collaboration of youth, a church, and the LGBTQ+ community—allowing young people to firmly see themselves represented in a place that’s important to them.
Megan said it best: “It [GISH] is supposed to be a competition, but really, the Hunt lowkey facilitates self-care and building your relationships.”

“Item 11: Listerine Mouse Wash.”
Ashley Northern of team Robotic Beeccaneers managed to include her adorable hairless rat Pyp in every GISH since 2017. She never wanted a hairless animal at all due to their generally low life expectancy—until Pyp fell into her lap. Ashley’s friend and former pet store coworker thought he was placing Pyp into an empty tank, but an aggressive hamster hiding in the cage attacked the friendly rat, causing her to lose an eye.
Ashley’s friend was in hysterics, as the pet store doesn’t tolerate “deformities.” He was convinced that Pyp, who could live just fine without an eye, would be sold as reptile food. He kept repeating, “You have to help me! I’ve killed her! I’ve killed her!”. Knowing that Ashley couldn’t refuse an injured animal, he took her to the only person he knew would help. Ashley nursed Pyp back to health and the pair have been inseparable ever since.
She said, “Pyp has lived in my shirt every second that I am home since that day. As to those fabled health issues that all hairless animals get, she’s been one of the healthiest and longest-lived rat I’ve ever owned.” Rats are expected to live between one-and-a-half to two-and-a-half years, but Pyp turned three in May. She’s still going strong despite her senior citizen status.
Ashley went on to say: “GISH has meant so much to our relationship because it has given me priceless memories that I will cherish long after she’s gone. She’s been a chupacabra and an astronaut, she’s sampled a new line of Listerine Mouse Wash, and she’s proven to be an exceptional painter.”
She concluded with: “Last year, I made the mistake of saying 2018 would be her last year GISHing, as I had assumed she would have passed before 2019. This year, I’m going to make it my mission to give her the greatest senior care any rat has ever seen with the goal of getting her to GISH 2020!”
We’re not crying. We just have Lysterine Mouse Wash in our eyes.

“Item 83: The London Zoo has a pair of penguins who are out and proud, but they didn’t get to march in Pride because they are penguins in a zoo. We think that’s just wrong. Dress up in penguin suits and march through your town with rainbow flags to show your support for Penguin and LGBTQIA+ Pride.”
Nothing gives people the opportunity to be a little weird while taking a stand for something important quite like GISH. All penguins deserve a Pride parade and Dana, of team KissAGish (GISH 2018 runner-ups), rose to the challenge.
Dana said, “I’m a queer mom to a trans kiddo that came out this year, so I was super excited to do this photoshoot with my friend, who is also LGBTQ+. We laughed the entire time and had children coming up to us for hugs and high fives as if we were costumed Disney characters.
While Dana’s daughter is quiet and doesn’t like attention, she was happy to work the camera. Dana noted that her daughter had more fun this GISH than she’s had in the past—especially pouring syrup and edible glitter on her mom. Honestly, who wouldn’t have fun dousing their parents in syrup?

“Item 32: We’re putting you in charge of Supernatural canon for the day. Paint a cannon with an elaborate SPN mural showcasing something that you think should be canon, with a caption like, ‘It’s #SPN Cannon!'”
Supernatural is most known for being the show that kills everyone. Sometimes, the characters come back to life and sometimes, they don’t. Kirsten Hoba of Team # decided to paint her favorite fallen characters on a cannon at the University of Guelph. She painted around the muzzle of the cannon as if the characters were all sitting around a roundtable for dinner. Excuse us while we wipe away our classic TV single man tear.
Whether it’s passing the salt for demon hunting purposes or cholesterol clogging intentions, the cheeky hashtag works (Kirsten’s teammate Rebekah Rolan came up with it). Kirsten noted that the British naval gun known as “Old Jeremiah” is technically supposed to be painted between sunset and sunrise, but GISHers are nothing if not rulebreakers

“Item 213: @dog_rates on Twitter & @weratedogs on Instagram rates dogs on their inherent dog attributes, but you know there’s a dog at your local shelter that deserves a 13/10 would take home forever rating.
Go to your local shelter and identify the dog that has been there the longest or is most in need of a home. Take appealing photos or videos of your canine candidate and create the best, most shareable post you can of this good doggo, including information on how and where to adopt them.”
About a month before the hunt, Breanna Harrel’s parents lost their 20-year-old pit bull, Occie. Her parents, Renne and Mike Herrel, wanted to open their home to another dog, but planned to wait until the renovations to their house were complete. That’s when Breanna met Brutus. She went to CARE Animal Rescue in Springfield, Missouri where she was taken to the two dogs who had been in the shelter the longest. She noticed that one of them was a pit bull, and Breanna immediately knew which dog she had to post about. Pit bulls have a hard time getting adopted in general, but even more so with restrictions in the Springfield area.
Breanna convinced her parents to come to the shelter even though they weren’t planning on adopting yet, but like their daughter, they kept coming back to Brutus. The shelter volunteer was excited to introduce Brutus to Renne and Mike. After hanging out with the pup for a bit, her mom said, “It just felt right.” Brutus won over the Harrel family with both parents noting that Brutus is the sweetest, most intelligent dog they’d ever met. Of course, they ended up adopting him.
Mike said, “Since we got him, there’s no lack of love we’ve shown him, but he’s given it right back. We’re really blessed to have found him.” The Harrels say their home feels like a home again. We didn’t have to look hard to find a Gisher who ended up adopting the dog they posted about. With a group this dedicated to spreading kindness and love, it was inevitable.

“Item 193: A tiny painting of Misha and the Queen on a coin, made using toothpicks instead of brushes. – Arianne Elizabeth Llerena”
Misha Collins has a bit of an unconventional relationship with the Queen—in that he creates a weirdly intimate item every year with himself and the Queen. She may or may not even know he exists. We’ve all been there, Misha. It’s okay.
Jessica, of Team Flamboyance Loves Impala, is always first in line to humor Misha’s unhealthy infatuation with the Queen. While she had trouble getting the paint to stick on the coin, she prepped it with steel wool, sealed it with gesso, and then used her toothpicks to paint the coin. While it may look easy, rest assured, it’s not.

“Item 85: You’ve heard of a scarecrow, but let’s see a straw-stuffed scarevolleyballplayer at the beach.”
Most of us New Yorkers are used to getting judged for something as simple as wearing leggings with a T-shirt. Dany-el Baker of the VenomousNarwhals managed to set up a game of scarecrow beach volleyball without getting a single inquiry as to why anyone would do this.

Dany-el made sure that all of the clothing was purchased at a local charity shop and bought the straw from a farm store that supports local farmers. The scarecrows, aptly named Larry, Mo, Curly, and Joe, were advertised online and adopted by a local farming family. The squad will forever watch over their orchard.
Though, hopefully, there won’t be any ritual sacrifices to keep the crops healthy. Raise your hand if that Supernatural episode still gives you nightmares…

“Item 70: Over the years, Jensen Ackles has been depicted in Skittles, but we all know his character Dean loves pie. Let’s do a crossover: Bake a Skittles pie with a portrait of Jensen baked into the upper crust. Lattice work in the top crust should allow you to see the Skittles inside behind Jensen.”
Kathy U. from team High571 said: “Apparently, my ‘thing’ in this year’s GISH is putting Supernatural cast members’ faces on food.” Declaring herself “not a baker,” Kathy did a lot of research and prep work to create Jensen Ackles’ visage so elegantly on pie crust.
The task wasn’t without its trials. She almost cried when the cinnamon spilled after removing the first stencil. Her bravery stopped at baking the pie, though, as the baked skittles weren’t exactly appealing. It couldn’t taste that bad… could it?
Let us know later in the comments if you were brave enough to try your skittles pie. Hopefully, there weren’t any pie-related trips to the ER.

“Item 44: Recreate a Civil War-era photograph with Captain America, Iron Man, and/or their respective sides using the Woodburytype photography technique. As always, no Photoshop allowed unless specified. This one does not allow it.”
Traci Akierman of the Illusive Yetis pulled off this rendition of the Woodburytype photography technique with a lot of trial and error. Created by Walter B. Woodbury in 1864, the technique was originally created for illustrating books.
The resulting photographs—which are developed using gelatin, UV lighting, and photo negatives—create a hyper-realistic monochromatic photo. Traci said, “This was an adventure!… It’s a shame that I didn’t have time to fully dry my print before GISH was over because it looks even better once it dries.”

“Item 97: 8554J46H+FH. You, the Carrot God, have summoned them.”
The Illusive Yetis’ Patty Liu has been eating barely anything but carrots since accomplishing this item. The riddle at the beginning contains the coordinates to Bunnyhenge, a sculpture installation in Newport Beach, California. GISH releases a slew of bizarre rules before the Hunt known as the Commandments. After heading up to Bunnyhenge the first time, Patty’s team realized that all carrots must be used as wind instruments.
With her three bags of multicolored carrots useless, Patty said, “I have roasted the carrots, I have made carrot soup, next I need to make carrot cake or carrot bread. I am so done with carrots!”

“Item 138: The most stressful spa environment ever. – Lynette”
Ashley Morris, of team Otternauts, teamed up with her husband Andy Morris and their friend, Daniel McDonald, to put together this work of art. Andy manned the camera while Ashley got “pampered” by Daniel and his machete.
Daniel buys masks from Composite Effects every Halloween. As huge horror buffs, he and Ashley stock up on elaborate decorations from Vancouver’s Thomas FX.
Ashley said: “Big thanks to Daniel’s parents for letting us get weird in their backyard. We just had a great time doing this one… laughed ’till we cried, which is the whole reason for doing it, right? Just take a week off from normalcy to have fun, raise money, awareness, and be weird. Also, any excuse to get our horror on, we’re in!”

“Item 21: You’re a real dish. No, really. You and a friend, dressed as commemorative collector plates, donating platelets (that’s what plates bleed).”
Amy, from team MomsOnFire, and her mom went all out for this item. As per GISH’s trend to help people, there’s always a blood donation item—or something in the same vein.
Amy said: “The platelet donation item was one of my favorites. I’m already a regular platelet donor, so I jumped at the chance to donate during GISH. I scheduled the donation for my birthday and dragged my mom along with me. I gave my mom a choice of plates. She obviously went with Princess Di.”
Amy continued with, “The ladies at the blood bank got a kick out of it. One of them even took some pictures with her own phone and submitted it to their marketing team.”
The photo was shared by the blood bank, Vitalant, on social media. Vitalant told Amy that the post was their most popular one in a while, which hopefully encouraged more people to donate.
People might surprise you with how willing they are to get on board with bizarre activities like GISH—especially when they hear about all of the good it’s putting out to the world.

“Item 42: TWO PICTURES SIDE-BY-SIDE IN ONE IMAGE. I always feel a lot of guilt about the tattoo items in GISH. The first time I added one, I thought it was funny until I saw the tatts and then I felt a little bad.
Of course, it gives me a rush of power when I see them in person, and many of them are actually very cool… So I have an idea that allows me to keep feeling powerful, but takes away all of my guilt: Get a tattoo of the encouraging message you wish your higher self had written to get you through the tough times.
Because I know many of you already have inspiring tattoos, you must submit two images. The first is an image of you getting the tattoo when you are halfway done at the tattoo parlor, in the chair, holding a sign that reads, “GISH made me do it.” The second image is of the finished tattoo.
If you can, include your triumphant face. (Don’t include more than 2 images in your submission. Just one image with two photos side by side.)”
There should be a Commandment next year to make Misha Collins write brief item descriptions. For some context on what some of his previous tattoo items have been, he once made people get tattoos of themselves getting tattoos… and people actually did it.
This time, he was a little less cruel, and some teammates even fought over who got to do the item.
Dylan Caçador, from team BassackwardsLovesRoadapocalypse said: “Anyone who knows me knows this is huge. I have a fear of needles so intense, I can’t even look at them on TV without shaking or falling into a full-blown anxiety attack.”
He continues with, “But I’ve wanted tattoos for most of my life and this one specifically for the past two years. It took a lot of planning, a double dose of my as-needed anxiety medication, and a huge amount of love and support from my team.”
For anyone unfamiliar, Dylan’s tattoo is a reference to a tagline that’s been used for GISH for several years—We create, therefore we live. It’s always posted on official GISH accounts right as the clock runs out. The Hunt heavily emphasizes artistic expression and defying the status quo, making it the perfect expression to use.
Dylan went on to say, “Shortly after the hunt, the confidence I gained actually gave me the strength to finally go get a blood test I had been putting off for years, regardless of how detrimental it’s been to my health. I’m still very, very scared, but it seems just a little more manageable now that I’ve taken these huge steps forward.”
Dylan’s tattoo design was drawn and inked by Liz Chomka at The Art Den in Woonsocket, Rhode Island.

This writer also got a tattoo done. Inspired by a recent diagnosis of Bipolar Disorder and a late-night of rum and crying over The Spice Girls (TSG) not touring in the States, the idea of a ’90s tattoo was born.
The tattoo had to feature a Britney Spears and TSG mashup quote. The first half was taken from TSG lyric, “You gotta show what you feel, don’t hide.” The second half came from a Britney Spears interview where she said, “I just am.” The quote, of course, wraps around a ’90s choker design and the flower is from Britney’s first CD.
Britney Spears gets a reputation of being a typical unintelligent “Valley Girl” (despite being from Mississippi), but when people actually listen to what she says, she’s a remarkably wise and self-assured woman. ’90s Power Girls are huge proponents for being unapologetically who you are. In a world where mental health gets belittled and people get bullied for being who they are, it’s helpful to have a reminder that you don’t need to be anyone but who you are. Don’t hide. Just be.
The tattoo was designed by talented Built On Hope teammate and graphic designer, Sami Nielson. She spent hours in back-and-forth sessions of quickfire ideas. The bottom of the photo is the design and the top is the final product, tattooed and slightly altered by Mikel at Uncharted Tattoo.

“Item 90: It’s an ineffable Good Omen to see Aziraphale and Crowley sharing a hot fudge sundae on Sunday. Post your picture on social media tagged #GoodOmens and @neilhimself. Bonus points if the sundae is eaten at a Sundae School on Cape Cod.”
Good Omens has swept the internet as a new fan-favorite TV show. Misha Collins usually creates a few current pop culture items, and really, what doesn’t David Tennant slay in?
Roommates from team Illusive Yetis, Megan Hobza and Cynthia Nalbach, spent two months prior to the Hunt building a 2-D cafe for fun photoshoots. While unplanned, it worked perfectly for the Good Omens sundae shop. Their cosplay friends, William Blumberg and Finley Miles Reid came ready to play two of their favorite characters in fiction.
The roommates said, “It was about 100 degrees out that day, so to prevent a messy meltdown during the shoot, we made the ice cream “sundae” out of mashed potatoes and shaving cream. The cherries are real, though!”
Most food commercials and marketing materials are created with the same kind of creative illusions to look plump and delicious.
“Item 106: A bacterial culture petri dish portrait of Jonas Salk. Tweet this to Melinda Gates thanking her for her work vaccinating children.”
Most teams that accomplished this item either did it with paint (guilty) or DIYed some bacteria creations. A teammate from Big Test Icicles works in an actual lab, so she was able to get fancy with the item. She said: “I’m kind of a hermit at work, despite being in an open lab. I have never cultured bacteria (at least not on purpose), so I needed help with making agar, how to incubate them, and what to use to draw my portrait…”
She went on to say, “I went to work on my vacation and it helped me push outside of my comfort zone about making requests, especially with something so silly. Everyone just laughed with me, though. I am a huge vaccine and science nerd, so I was thrilled to see a pro-vaccine science art item.” If anything is going to make people branch out of their comfort zones, it’s definitely the delightfully weird items on the GISH list. The new GISH tagline should be: “Turning introverts into extroverts since 2011.”

“Item 45: Why have chain letters, when you can have chain mail? Create an intricate medieval knight’s suit of armor entirely out of junk mail, with chain mail comprised of chain letters. Must include a junk mail shield, sword, and a codpiece (to protect your “junk”).”
Lorna from team Dues Ex Mishina said: “This is my eighth and final hunt as it’s time to retire and move onto other things. However, this year has been my favourite hunt.” The Scotland native headed up to a local castle for the item, but she had to maneuver through a swarm of tourists to snag the photo. That’s a real mood. So many people kept trying to take her photo, she couldn’t get one in front of the castle and had to move to plan B for a graveyard gate photo.
Lorna had fun surprising people in her armor and definitely made some tourists happy. She said, “It was amazing to see the expressions on people’s faces when I appeared in my armor and I don’t think I will ever forget how much fun I had trying to get this item.”

“Item 38: Ugly Holiday sweaters are great, but with the climate crisis heating up the planet, we’ve got to branch out. Model your best ugly Holiday bathing suit or bikini made of repurposed ugly holiday sweaters. Model it at the beach with a caption touting the virtues of your ‘Global Warming Holiday Sweater.'”
Tanya Tyson and her son Zayde, from team Gish on the Wind Loves Dean’s Perky Nipples, almost traveled to the North Pole to accomplish this item. Santa would be proud. The mother-son duo trekked to Portage Lake, which is about 60 miles South of Anchorage, Alaska. The lake is glacier fed by Portage Glacier.
Tanya said: “The fact that you cannot see the glacier from the Visitor Center area is a testament to the fact that the glaciers are melting—likely more quickly due to global warming.” She continued with, “According to signs in the Visitor Center, the glacier was visible from that area around 20 years ago. People do not normally swim in this lake, but my son was willing to go in for a photo opportunity.”
Nicole Lazar, from team CrowleysHellhounds, also completed this item. She said, “I love doing tasks with my children. Occasionally, my oldest gets embarrassed, but on the whole, we have a lot of fun, bonding time during GISH week… My two-year-old insisted on wearing her holiday bikini around the house for days before we made it to the beach for photos.
If GISH can make an item that’s both satirical and stands for something, they absolutely go for it. This was one of the more clever and fun, yet sobering when you actually ruminate on the implications. It’s a great way to engage people into having conversations about such matters.

“Item 1: Make an Assbutt of yourself in public. Literally.”
As the last season of Supernatural approaches, (cue a single man tear), GISH chose an Assbutt as this year’s mascot—one part donkey and one part butterfly… get it? The GISH mascots are always a bizarre mashup of two animals, but this one holds a special place in the hearts of fans.
In season five, Misha Collins’ character Castiel yells, “Hey! Assbutt!” at Satan himself. The line became one of the most iconic phrases from the show. To honor the final season, GISH brought the quote to life with this year’s mascot.
Goats! Goats! Goats! teammate Gail Porter said: “The wonderful ‘old’ lady being harassed is Gael. She owns Stages Costume Shop in Wheeling, West Virginia. She helps me with costumes, picture taking, ideas, or anything I need during the Hunt—a friend I made purely from playing GISH.”
This is yet another example of GISH bringing people together. Through GISH people are forced to branch out of their normal circle. This gives everyone a chance to meet people they wouldn’t have crossed paths with had it not been for this wacky week-long event. Friendships from around the globe are forged virtually and in-person during GISH and beyond. You can’t put a price on friendship.

“Item 61: (F)underwear.”
GISH always has an underwear item. Always. The item this year left a lot to interpretation, which can admittedly be a bad idea when it comes to GISHers, but Ciara Mealer kept things lowkey. She said: “It should be noted that we live deep in the conservative south, in a very small town… Due to the hectic nature of GISH, I had to make a costume change in the parking lot…”
She continued with, “Needless to say, though, we certainly got some looks from the young men just trying to play a game of DnD [Dungeons and Dragons] that afternoon. To their credit, blushing and quickly averted gazes were the only reactions to our weird and wonderful photoshoot.” The photo was taken at OCM Comics & Collectibles/The Artful Barn in Clarkesville, Georgia. Apparently, someone named Karen Johnston is taking credit for the mural art that was done by an artist known as Nack. Not cool, Karen.

“Item 153: I said no more ponies in the living room, and I meant it! But unicorns are totally okay.”
Prior to the Hunt, Commandment 52 declared that “Toilet-trained ponies may be allowed in the living room, but chickens are still prohibited without a waiver.” Barn animals have frequently appeared in tasks, so prior to the Hunt, the GISH community was abuzz with what this could mean. Everyone knew there had to be an item this would reference. The super-sleuths that GISHers are, there was.
After talking to a pile of friends of friends of friends, Kristin Nichols of CrazyCassLadies finally found someone to help her out with the task. Getting a stranger to let you bring their horse into your living room requires some pretty heavy blind faith. Kristin said, “My daughter Olivia is four and is very much a Disney Princess. I told her a unicorn was on its way to our living room and she got really excited. She asked to change into her purple princess dress.”
When Wrigley and his owner got to their house, Olivia met them in the front yard. She was abuzz with adrenaline and excitement, as she’d never seen a horse up close before—let alone a unicorn. Olivia and Wrigley share a love of candy canes, and both enjoyed it when Olivia fed him their favorite treat.
Inspired by a unicorn chilling in her living room, (honestly, who wouldn’t be?), Olivia’s new passion is horses. She pet every single horse at the fair and used all of her money to ride the horses. She grinned the whole time. Kristin added, “The item only took five minutes, but it changed my daughter’s whole life. It made her so happy, and I’m forever grateful that we were able to fit a unicorn in our living room.”
Ugh, if only we could get horses into New York City high rises, we’d all be a little less grumpy.

Item 59: Cement your own joy.
If GISH doesn’t make you cry 1,000 times, did it even happen? Brenda, from team WaywardWendigos, said: “My dogs are my life. They are foster failures and have been with me through so much the past few years. I lost my eldest in May and it broke my heart that I never got her pawprints—I miss her every day.”
She continued with, “When this task came up, I knew it was the perfect time to get my remaining two girls’ prints permanently cemented.” And so she did. These aren’t tears. It’s just the Mousewash again, okay?

“Item 190: Evolution of the selfie:
A person with an iPhone taking a selfie next to a person with a point-and-shoot camera who is taking a photo of a person with a Polaroid camera who is taking a picture of a person with a 35mm camera who is taking a photo of a person with a daguerreotype camera taking a picture of a person with a camera obscura taking a picture of someone painting a self-portrait.
This should be a single photo, not photos from each camera.”
This item was like breaking the 20th wall. Laura Martin and Angela Mott of team PandasLoveRaivers went through a lot to find all of the required cameras for the photo. Angela even hit up her ex-husband for their old point-and-shoot camera. She said, “There were phone calls and driving and chasing. This was actually the true spirit of the scavenger hunt.”
Angela’s entire Bellydance crew called the Sonic Rainbooms and another called Dyad got on board to pose for the photo. They went through possible period costume ideas, but they ultimately decided to go with their Bellydance costumes to make the photo pop with color. The drama of this photo truly embodies the spirit of GISH.

“Item 147: COLLABORATIVE. The evening of Sunday, July 28 is the event of the year: the #WeJustMetGala! Get together with Gishers in your area at your local museum in the strangest, fanciest attire you can create—go so all-out, you make Billy Porter jealous.
Roll out the red carpet and a banner, then convince strangers passing by to pose with you for red carpet pictures. Be fabulous! We must see the museum in the background, and there must be paparazzi.
Post your images and videos to social media and tag #WeJustMetGala, #GISH & @theebillyporter, then submit your image or video to us with the link to your social media post in the comments.”
GISH is basically a runway of weird on a normal day, but this year, it was literally a runway. The Hunt always has collaborative items prompting local teams to meet up and make things weird together. Mel, from team FlamboyanceLovesImpala1967, headed to the de Young museum in San Francisco for her We Just Met Gala photo shoot.
Mel said, “This year, I was really having trouble finding my GISH spirit, but kicking off Sunday night of the Hunt by meeting up with other teams at such a beautiful location, and witnessing everyone’s willingness to smile at strangers and be silly was exactly what I needed.”
She continued by saying, “Every time GISH rolls around, I’m grateful for how it has helped me overcome years of self-criticism, resistance, and unhappiness about seeing myself in photos. Through six years of GISH, I’ve grown into being able to look at myself with more love and acceptance.”
That’s just one example of GISH inspiring body positivity and self-love in people all around the world. This wild scavenger hunt and its baffling tasks inspire people to be the best people they can be and love themselves for who that person is.

“Item 157: A hand-made kite that looks just like the face of that famous person you look up to, high in the sky.”
This item was harder than it looks. Following the pattern of failing to get a fifth-grade kite to fly, the attempt to fly Princess Leia was equally unsuccessful for team Built on Hope. Rebecca Palmer, from team Riptide, had much more success… eventually. She said, “I admire Colin Kaepernick for using his platform to bring attention to the tragic injustice faced daily by people of color in this country [the United States].”
She noted, “He increased the dialog about racism, even among people who are often unaware of their privilege, myself included.” Rebecca and her sister attempted to get the kite flying, but they were eventually assisted by a nearby family after 30 minutes of failure,
Rebecca went on to say, “Kaepernick has taught me about sacrifice and about hardships and injustices I will never face. I still have work to do in unpacking my privilege and fighting to end the system of white supremacy, and I will continue to do this work and support the fight against racism. I’m Team Kaepernick… Representation matters.”

“Item 145: Mary Poppins and the Demogorgon from Stranger Things both loved hanging around in the Upside down! Create a convincing image of you having upside-down high tea on the ceiling with Mary Poppins and a Demogorgon. Post it to social media and tag the Stranger Things accounts and GISH. – Inspired by TessaMac”
Stranger Things is another recent pop culture obsession that’s taken over the world since its 2016 debut. Jeremiah Lutes, Christine Barger, Amanda Marie, and Allishia Knotts headed to the Museum of Illusions in Hollywood, on behalf of their team called #.
After getting all of the costumes together, Christine realized that she had to be in the photo along with her husband as the Demogorgon and Amanda as Mary Poppins. Christine said, “I was covered in dirt and sweat in my ratty jeans from building a giant sock monkey at the park earlier that day and hadn’t brought a change of clothes. Luckily, Allishia lived nearby and offered to let me borrow a dress, so we ran to her place and quickly changed.”
Christine commented further, “We made it back and the museum gave us access to the upside-down house for the photo. Huge thanks to my friend and helpers and the Museum of Illusions for making this so wonderful.” Honestly, GISH isn’t GISH if 9,000 things don’t go wrong, but if Christine couldn’t find a dress, she could just blame the Demogorgon. Is there one scene with the beast that doesn’t have a character caked in dirt and blood?

GISH is all about creating change for the better in the world as a whole, but also in the lives of participants. Team CookieMonster’s leader, Exquisitely Loveable (her GISH username), was especially touched by Item 120.
“Item 120: Neil Armstrong stepped on to the Moon 50 years ago. To memorialize this amazing achievement, make your own “One Small Step” monument. Take a giant leap for mankind and put your foot somewhere it’s never been before and probably should not go, then show us the resulting footprint.”
ExquisitelyLoveable knew right away that her foot should(n’t) go in Jello. She said, “My youngest son, who has come to learn about and love his mom’s enthusiasm for Misha and for all things GISH, actively avoids new sensory situations—except for this time. He watched his mom stick her foot in the Jello and laugh and then he asked if he could do the same. And he did! It was a big step for me and a Giant Leap for him!”
Katy Futrell, of team WhiteSquirrels said: “I’ve been dealing with a lot recently and it has drained my creativity. I was assaulted back in June and I’ve been feeling empty. It’s been a lot of battling with myself as to whether or not I’d even be able to make anything worthwhile this year.” Katy continued by saying, “This was the first time in months that I really felt like making something. Making things is in my blood.”
Katy did the item that required her to make a “bee bar” to help struggling bees get water. She said, “I’m so proud of it! It’s even still where I left it on my college’s campus, which makes me very happy. Plus, I got to help my favorite little friend [bees] out!”
GISH participant Emily’s kids love the elderly lady, Katie, across the street. One item tasked GISHers to create a diorama of an elderly person’s favorite day. The family enjoyed recreating Katie’s wedding and honeymoon for the item. At 96-years-old, the diorama made Katie’s day. Dakota, 19-year-old GISHer, said: “My great grandfather died about a month ago, and I live with my great grandparents. GISH is the only thing to have given me joy lately.”
GISH is more than a scavenger hunt. It helps heal hearts, encourages people to conquer their fears and try new things, it spreads creativity and joy, and most importantly, it helps make the world a better place.
Since the first year in 2011, the Hunt has spread far beyond the Supernatural fandom and fans of Misha Collins. It’s a global phenomenon of kindness and love for one week a year—but its impact has an eternal scope.
No matter what Misha Collins decides in the upcoming years—whether GISH goes on past when he’s done running it or not—the spirit of the Hunt lives on in everyone whose lives were changed for the better through this bizarre online scavenger hunt.
Collins surely didn’t foresee this incredible impact when he was doing a scavenger hunt at his college, but that one small act has spawned a movement of kindness and love that spans far beyond what anyone could have imagined.
GISH registration is closed for the time being, but if you are inspired to join, keep an eye on the GISH site and social media pages, as registration often opens up periodically until it gets closer to the Hunt. GISH 2020 will run from August 1 to 8. Gish on.
Next, check out The Top 28 Items From the Final “Greatest International Scavenger Hunt the World Has Ever Seen” and The Top 10 Ways to Celebrate New York Comic-Con in NYC. Get in touch with the author @LitByLiterature.
Subscribe to our free newsletter